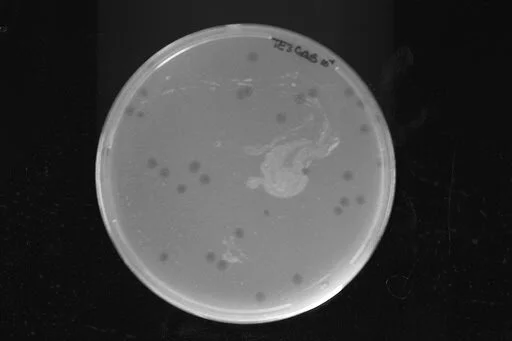
gui.jpg

Research

Sequencing Putative Genes associated with Helicobacter Pylori Virulence
Selected as one of three inaugural English-Stonehouse Research Fellows (Microbiology). This further funded ongoing research projects under Dr. Mark Forsyth’s Microbiology Lab focused on Helicobacter Pylori. Girolama’s project involved determining the sequence of a cryptic, partially deleted prophage sequence (a viral DNA sequence contained as a genetic parasite within a bacterial DNA genome). Girolama's work has helped show that this unusual viral DNA element may be present in isolates of a human stomach bacterium at frequencies higher than most researchers ever imagined.
Find data on my research here.

Howard Hughes Medical Institute SEA-PHAGE Researcher
Selected as one of thirty students to participate in the second cohort year at the College of William & Mary of this nation wide research effort lead by HHMI. The HHMI initiative is designed to give selected freshmen in-the-lab real research opportunities to learn techniques and concepts used in microbiology, molecular biology, genomics and bioinformatics. The researcher assistants are not just learning advanced biological concepts, but also are working to create new knowledge about phages and their genetic structure.

Cryptic Prophage Genome Walking
Just what looking for DNA looks like sometimes.
